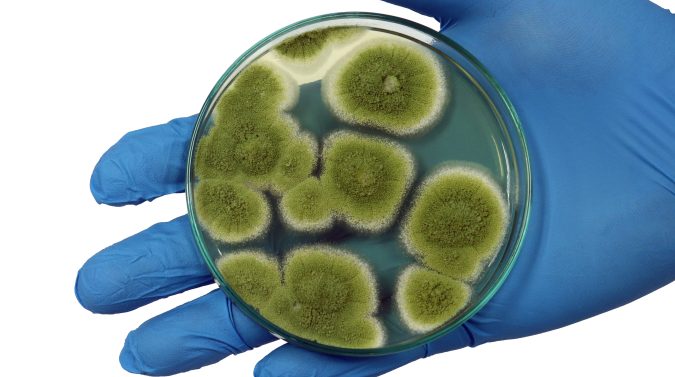

Cómo quitar el moho del auto: evita olores y problemas de salud
Evita malos olores y bacterias en el interior de tu auto con un sencillo método de limpieza casero. Elimina el moho y renueva los olores adentro del carro.

No derrames líquidos en los asientos o alfombras de tu auto para evitar generar moho en el interior. Crédito: Pixabay
No hay casi nada peor que encontrar moho en tu automóvil, pues además de resultar una experiencia desagradable, puede generar bacterias que pueden ser dañinas para tu salud. Además, no solo se ve y se siente desagradable, existe una gran posibilidad de que huela desagradable, por lo que es importante que atiendas de inmediato este problema.
Es casi inevitable: allí donde hay humedad, hay moho. Y es común que aparezca en el interior de tu carro, sobre todo si llevas un tiempo sin utilizarlo. Te contamos cómo puedes deshacerte de él.
Cómo quitar el moho del interior de tu auto para evitar malos olores
Los vehículos pueden llenarse de moho en el interior por una variedad de razones, pero la más común es una fuga de humedad. Sin embargo, con un poco de esfuerzo y tiempo, puedes quitar el moho, frotar el área y dejar que huela como nuevo.
Es por eso que para ayudarte a eliminar el moho y refrescar el aire dentro de tu automóvil. Compartimos algunos consejos que pueden ser de gran utilidad.
Es importante que uses protección para la piel, los ojos y sobre todo la respiración. Es posible que el moho en tu automóvil no parezca peligroso, pero es imposible saber los efectos que puede tener sin probarlo.
Si usas productos químicos para fregar o limpiar el interior de tu vehículo, asegúrate de desechar los materiales sobrantes de la manera recomendada por el fabricante. También es importante asegurarte de usar un limpiador que sea seguro para los materiales que componen el interior de tu automóvil.
Si el moho se ha extendido a otros elementos dentro de tu automóvil, como la ropa, es mejor lavarlos o desecharlos antes de usarlos o guardarlos en otro lugar. Es algo que ocurre con carros que se han inundado, por ejemplo.
Todo lo que necesitas para quitar el moho en el automóvil es:
- Una botella de spray.
- Toallas o trapos.
- Cepillo para fregar.
- Guantes.
- Protección para los ojos.
- Máscara.
- Vinagre blanco destilado.
- Toallitas de limpieza para automóviles.
El moho es algo desagradable y usarás productos químicos para limpiarlo, así que asegúrate de trabajar en un área bien ventilada.

Antes de que puedas comenzar a fregar o limpiar el moho, asegúrate de que el interior del automóvil esté al menos parcialmente limpio. Retira la basura, las pertenencias personales, el papeleo y otros artículos del interior. Desecha todo lo que tenga hongos. Recuerda también aspirar completamente las alfombras, los asientos y otros acabados suaves.
¿Cómo quitar el moho del carro?
1. Llena tu botella de spray con vinagre blanco destilado. Es esencial usar una nueva botella de spray si es posible, ya que cualquier residuo que quede dentro de la botella por un uso anterior puede causar problemas.
2. Rocía la solución directamente sobre alfombras, asientos y cualquier otra superficie donde haya moho. Satura bien el área.
3. Usa un cepillo para fregar para aplicar la solución de vinagre en el área afectada, rociando más si es necesario.
4. Deja secar las superficies. Si tienes un garage donde el automóvil se puede estacionar de manera segura en el interior, es mejor dejar las ventanas abiertas para permitir que el aire fresco entre y salga.

5. Si el moho es causado por algo que no sea agua o humedad, es posible que debas repetir este proceso para eliminar por completo los olores.
Para eliminar moho y olores más fuertes necesitarás realizar el proceso al menos tres veces, restregando y dejando secar el interior para eliminar por completo el mal olor.
Cómo quitar el moho de la alfombra del carro
De nuevo, para quitar el moho de la alfombra o la tapicería, humedece una toalla o trapo de limpieza con una mezcla de agua con cloro o alcohol en partes iguales. Con este trapo talla en las zonas donde veías que había moho. Repite el proceso un par de veces para eliminar el moho en la tapicería y que no haya riesgo de que aparezca más y dañe la tela.
Cómo eliminar el moho para siempre
- Mueve el coche fuera de la sombra e intenta que le dé la luz solar directa. Abre todas las ventanas y puertas durante al menos 20 minutos. Esto ayudará a que se sequen las zonas húmedas y a parar el desarrollo de la colonia porque el moho no puede crecer en condiciones secas.
- Localiza el área de tu automóvil donde se haya comenzado a formar el moho. Comprueba cualquier lugar con superficie porosa o absorbente, como asientos, alfombrillas incluso cinturones de seguridad. Utiliza una máscara contra el polvo porque aunque hayas dejado el coche al aire, puede todavía haber esporas por el interior que es mejor no respirar. Evalúa los daños y si se puede corregir comienza a raspar la zona afectada con un cepillo, con cuidado de no propagar las esporas alrededor.
- Un cubo de agua tibia y un shampoo de PH neutro. Una vez que has roto los grumos, toca limpiar. Frota para eliminar el moho restante tanto como sea posible. Asegúrate de que el coche tiene ventilación para lograr el secado. Después utiliza una aspiradora para eliminar cualquier espora resistente.
- También puedes utilizar vinagre o bicarbonato para limpiar las superficies afectadas. Si utilizas vinagre para esta operación, diluye ocho de partes de vinagre por dos de agua. Extiende una cantidad generosa y deja que se asiente durante unos 20 minutos hasta que haga su efecto, después retíralo con un trapo limpio. Si prefieres el bicarbonato, espolvorea por la zona afectada, deja que el producto se asiente aproximadamente una hora y retíralo. El bicarbonato no solo es un magnífico limpiador sino que ayuda a eliminar el olor creado por la humedad.
- Nada de lejía o amoniaco. Estos productos solo eliminan la mancha, pero de un modo superficial incluso puede alimentar al moho, en el caso del amoniaco, y empeorar la situación. Hay productos profesionales disponibles en la mayoría de las ferreterías por 4 euros que son específicos para este problema.
- Limpia también el área de alrededor de su crecimiento. Las esporas de moho no siempre son visibles por lo que deberás limpiar, además de la ubicación exacta, el área de alrededor por si hubiera restos que no se ven a simple vista.

No olvides quitar el moho de la carrocería
Aunque parezca increíble, el moho también puede aparecer en la carrocería del auto, y más si no lo has utilizado durante ya un tiempo. No te preocupes: como explicamos, puede ser removido de manera fácil y rápida. Pero recuerda utilizar elementos de protección, como guantes de látex y lentes transparentes.
Cómo afecta el moho tu salud
Además de ser muy desagradable a la vista y al olfato, el moho puede resultar perjudicial para la salud, ya que sus esporas pueden provocar irritación en la piel, ojos y garganta, entre otras afectaciones.
El más peligroso es el conocido como ‘moho negro’ (Stachybotrys chartarum and chlorohalonata), es tóxico y tiene una larga lista de afecciones, entre las más graves se encuentran fatiga y debilidad, dolores de cabeza, mala memoria, dificultad para respirar, dolor y distensión abdominal y puede incluso causar algunas reacciones alérgicas severas.
Por eso es tan importante eliminarlo lo antes posible.

TE PUEDE INTERESAR: